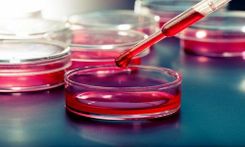

Özgeçmiş
Marmara Üniversitesi Hematoloji Bölümü'ne asistan olarak girmiştir.ABD’de Louisville Üniversitesinde Hematoloji-Onkoloji yan dal ihtisasını tamamladıktan sonraTürkiye’ye dönerek 2000’de Kadir Has Üniversitesi’ne profesör olarak atanmıştır. Aynı üniversitede Tıbbi Onkoloji Bilim Dalını kurmuştur. Daha sonra TC İstanbul Bilim Üniversitesine geçiş yapmıştır.
Prof. Dr. Tecimer 21 yıl Gayrettepe Florence Nightingale Hastanesi Hematoloji-Onkoloji Bölümü'nde çalışmıştır. Şu anda İstanbul Florence Nightingale Hastanesi'nde hastalarına hizmet vermektedir.
Hem Türkiye hem de Amerika ve Avrupa’da hakemli dergilerde Türkçe ve İngilizce olarak yayınlanmış bir çok tıbbi makalesi ve kitap bölümü bulunmaktadır.
Yayınlar:
1. Uluslararası hakemli dergilerde yayınlanan makaleler
1-Tecimer C, Oram Y, Tecimer T. Lupus vulgaris in a patient with pulmonary tuberculosis. Cutis 1994; 53:246-8.
2- Tecimer C, Yam LT. Surreptitious superwarfarin poisoning with brodifacoum. Southern Medical Journal 1997; 90:1053-5.
3-Tecimer C, Loy BA, Martin AW. Acute myeloblastic leukemia (M0) with an unusual chromosomal abnormality: Translocation (1;14) (p13;q32). Cancer Genetics and Cytogenetics 1999; 111:175-7.
4- Tecimer C, Doering D, Abdulhay G, Goldsmith J, Meyer JS, Wittliff JL. Clinical relevance of urokinase-type plasminogen activator, its receptor and inhibitor type 1 in ovarian cancer. International Journal of Gynecological Cancer 2000; 10:372-81.
5- Tecimer C, Doering D, Abdulhay G, Goldsmith J, Meyer JS, Wittliff JL. Clinical relevance of urokinase-type plasminogen activator, its receptor and inhibitor type 1 in endometrial cancer. Gynecologic Oncology 2001; 80:48-55.
6- Alço G, İğdem Ş, Dinçer M, Tecimer C, Şentürk R, Vural M, Okkan S. Gemcitabine induced radiation recall myositis: Report of two cases. International Journal of Hematology and Oncology 2009; 19: 249-253.
7-Akun E, Okutur K, Seber S, Korkmaz T, Aydın K, Bozkurt M, Namal E, Hasbal B, Tecimer C, Demir G. Safety and tolerability of first-line bevacizumab in metastatic colorectal cancer. Journal of Balkan Union of Oncology 2012; 17: 669-76.
8- Ordu Ç, Pilancı KN, Köksal Üİ, Okutur K, Sağlam S, Tecimer C, Demir G. Can megestrol acetate induce thrombosis in advanced oncology patients receiving chemotherapy? Asian Pacific Journal of Cancer Prevention 2014; 15: 10165-9.
9- Ordu Ç, Pilancı KN, Avcı N, Yıldız İ, Demirhan Ö, Alço G, Köksal Üİ, Elbüken F, Sağlam S, Tecimer C, Demir G. Prognostic relevance of sunitinib toxicities and comparison of continuous vs intermittent sunitinib dosing schedule in metastatic renal cell cancer patients. Contemporary Oncology 2016; 20 (2).
10-Okutur K, Başsülü N, Dalar L, Aydın K, Bozkurt M, Pilancı KN, Doğusoy GB, Tecimer C, Mandel NM, Demir G. Predictive and prognostic significance of p27, Akt, PTEN and PI3K expression in HER2-positive metastatic breast cancer. Asian Pacific Journal of Cancer Prevention 2015; 16: 2645-51.
11-Pilancı KN, Alço G, Ordu Ç, Sarsenov D, Çelebi F, Erdoğan Z, Ağaçayak F, İlgün S, Tecimer C, Demir G, Eralp Y, Okkan S, Özmen V. Is administration of trastuzumab an independent risk factor for developing osteonecrosis of the jaw among metastatic breast cancer patients under zoledronic acid treatment? Medicine 2015; 94: e671.
12- Pilancı KN, Elüken F, Ordu Ç, Köksal G, Tekelioğlu MH, Okutur K, Göksel S, Köksal Ü, Alçal T, Tecimer C. A rare case of sunitinib-induced hyperammonemic encephalopathy and hypothyroidism in metastatic renal cell carcinoma. Am J Ther 2016; 23(2).
13- Alço G, İğdem S, Dinçer M, Özmen V, Sağlam S, Selamoğlu D, Erdoğan Z, Ordu C, Pilancı KN, Bozdoğan A, Yenice S, Tecimer C, Demir G, Köksal G, Okkan S. Vitamin D levels in patients with breast cancer: importance of dressing style. Asian Pac J Cancer Prev 2014; 15: 1357-62.
14- Tavukçu HH, Aytaç O, Aktepe F, Atuğ F, Erdem L, Tecimer C. Ductal adenocarcinoma of the prostate with a rare clinical presentation: late gastric metastasis. Tavukçu HH, Aytaç O, Aktepe F, Atuğ F, Erdem L, Tecimer C. Urol Case Rep 2016; 7: 28-30.
2. Uluslararası bilimsel toplantılarda sunulan ve bildiri kitabında (Proceedings) basılan bildiriler
1- Oto A, Tecimer C, Oram E, Uğurlu Ş, Karamehmetoğlu A, Oram A. Disturbance in the autonomic control of the heart rate in patients with acute myocardial infarction. Mediterranean Association of Cardiology and Cardiac Surgery 1st Annual Meeting, Cavtat-Dubrovnic Yugoslavia, October 8-11, 1987. Abstracts, 199.
2- Alpdoğan O, Budak-Alpdoğan T, Tanrıverdi S, Tecimer C, Fıratlı-Tuğlular T, Bayık M, Akoğlu T. The efficacy of mega-dose methylprednisolon treatment in patients with idiopathic thrombocytopenic purpura. The 13th Meeting of the International Society of Haematology (European and African Division), İstanbul, September 3-8, 1995. Abstract Book, Abstract No: 697.
3- Tecimer C, Bhupalam L, Djulbegovic B. Is standard heparin superior to low molecular weight heparin in malignancy related deep vein thrombosis? The 39th Annual Meeting of the American Society of Hematology, San Diego, CA, December 5-9, 1997. Blood 1997; 90: 124b.
4- Wittliff JL, Smolenkov AS, Tecimer C, Schmitt GA, Tuckson WB, Galandiuk S.
Expression of urokinase-type plasminogen activator (uPA), its receptor (uPAR) and its inhibitor (PAI-1) in Russian and American patients with colon carcinoma. The Meeting of the Clinical Ligand Assay Society, New York, NY, Spring 1998. J Clin Ligand Assay 1998; 21: 87.
5- Tecimer C, Doering DL, Meyer JS, Abdulhay G, Goldsmith LJ, Wittliff JL. Prognostic significance of uPA, uPAR and PAI-1 expression in the management of endometrial cancer. The 35th Annual Meeting of the American Society of Clinical Oncology, Atlanta, GA, May 15-18, 1999. Proceedings 1999; 18: 160a.
6- Dane F, Yumuk PF, Turhal NS, Ekenel M, Başaran G, İyikesici MS, Tecimer C. FOLFOX 4 in metastatic colorectal cancer (MCRC) patients who progressed after infusional 5-FU/irinotecan based combination regimens. The 40th Annual Meeting of the American Society of Clinical Oncology, New Orleans, LA, June 5-8, 2004. J Clin Onc, 2004; 22: 301S.
7- İğdem Ş, Altın M, Alço G, Ercan T, Kara B, Ünalan B, Tecimer C, Köksal G, Turkan S, Okkan S. PET/CT guided, dose painting IMRT for nasopharyngeal carcinoma. Proceedings of the American Society for Therapeutic Radiology and Oncology 50th Meeting, 21-25 September, 2008 Boston, MA. Radiation Oncology Biology, Physics 2008; 72: S424-5.
8- Okutur K, Turan C, Tecimer C, Demir G. Toxicity of bevacizumab (BV) in metastatic colorectal cancer (MCRC): Data from clinical practice. 7th Congress of B.U.O.N., 16-19 October, 2008, İzmir, Turkey. Journal of B.U.O.N. 2008; 13 (Suppl 1): S31.
9- Okutur K, Demir G, Tecimer C, Erdem L, Turan C. Toxicity of bevacizumab in metastatic colorectal cancer: Data from clinical practice. Poster presentation. 18th International Postgraduate Course of the International Association of Surgeons and Gastroenterologists and Oncologists, October 2008. Hepatogastroenterology Current Medical and Surgical Trends 2008; 55 (Suppl 1): S165-6.
10- Okutur K, Aydın K, Bozkurt M, Turan C, Demir N, Hasbal B, Erdem L, Tecimer C, Demir G. Toxicity of bevacizumab in metastatic colorectal cancer: Data from clinical practice. 1st Congress of the Mediterranean Multidisciplinary Oncology Forum, 10-13 September 2009, Athens. Abstract 28.
11- İğdem Ş, Altın M, Alço G, Ercan T, Ünalan B, Tecimer C, Köksal G, Gürses K, Demir G, Okkan S. Whole field simultaneous integrated boost IMRT in nasopharyngeal cancer. I J Radiation Oncology Biology Physics 2010; 78: S478.
12- Başaran G, Sağlam S, Tansan S, Demirel M, Gökmen E, Aktan S, Göker E, Kaban KK, Saip P, Demir G, Bavbek SE, Mandel NM, Tecimer C, Turhal NS, Garipoğlu M. The impact of 21-gene recurrence score (RS) scores on treatment decisions. Retrospective evaluation in Turkish early-stage breast cance (BC) patients. The 47th Annual Meeting of the American Society of Clinical Oncology, Chicago, IL, June 3-7, 2011. J Clin Onc, 2011; 29: Abstract No:e11042.
13- Bozkurt M, Okutur K, Aydın K, Namal E, Öztürk A, Tecimer C, Akçalı Z, Demir G. The impact of early thromboembolic event on prognosis in cancer parients: A single-center analysis of 1838 patients. The 47th Annual Meeting of the American Society of Clinical Oncology, Chicago, IL, June 3-7, 2011. J Clin Onc, 2011; 29: Abstract No:e19694.
14- Pilancı KN, Ordu Ç, Okutur K, İner Koksal Ü, Sağlam S, Tecimer C, Demir G. 17. European Cancer Congress, Amsterdam, 27 September-1 October 2013.
15- Alço G, İğdem Ş, Dinçer M, Özmen V, Demir G, Köksal G, Tecimer C, Selamoğlu D, Pilancı KN, Okkan S. Can megestrol acetate induce thrombosis in oncology patients? 17. European Cancer Congress, Amsterdam, 27 September-1 October 2013.
3. Ulusal hakemli dergilerde yayınlanan makaleler
1-Oram A, Tecimer C, Oto A, Karamehmetoğlu A, Oram E, Uğurlu S. Akut miyokard infarktüsünde kalbin otonom sinir sistemi tarafından kontrolünde değişimler. Kardiyoloji 1988; 1:120-4.
2- Tecimer C. Kemik iliği transplantasyonu. Türk İlaç ve Tedavi Dergisi 1990; 3:528-30.
3- Tecimer C. Gastritis ve Tedavisi . Türk İlaç ve Tedavi Dergisi 1990; 3:585-91.
4- Durmaz R, Tecimer C, Durmaz B, Temel İ, Günal S. Concurrent hepatitis B surface antigen and antibody. Doğa Tr J of Medical Sciences 1992; 16:785-9.
5- Tecimer C, Pehlivan E. Enalapril ve kaptoprilin antihipertansif etkilerinin araştırılması. Türk İlaç ve Tedavi Dergisi 1992; 5:552-8.
6- Tecimer C, Aydın EE, Pehlivan E. H2-reseptör antagonistlerinden ranitidin ve famotidinin doodenal ülser tedavisinde etkilerinin araştırılması. Türk İlaç ve Tedavi Dergisi 1992; 5:620-4.
7- Tecimer C, Durmaz R, Durmaz B, Temel İ, Ozdemir R. Akut hepatit B infeksiyonundan sonra uzamış anti-HBc IgM pozitifliğinin anlamı. Ege Tıp Dergisi 1992; 31:599-602.
8- Durmaz R, Tecimer C, Durmaz B, Gunal S, Temel İ, Kızılkaya N. Anti-HCV positivity among different groups in Malatya, Turkey. İnfeksiyon Dergisi 1992; 6:247-9.
9- Tecimer C, Durmaz R, Durmaz B, Temel İ, Aladağ M, Yoloğlu S. Malatya yöresinde hepatit B virus infeksiyonu. Gastroenterohepatoloji 1993; 4:61-6.
10- Tecimer C, Durmaz R, Durmaz B, Temel İ, Günal S, Aladağ M. Hepatitis delta virus infection among the different groups in the region of Malatya. Gastroenteroloji 1993; 4:257-9.
11- Tecimer T, Tecimer C, Dursun A, Akyol G, Haznedar R, Ataoğlu O, Üstün H, Aladağ M. Değişik hematolojik hastalıklarda kemik iliği retikülin düzeyi: 150 olgunun değerlendirilmesi. T.C.D.D. Hastaneleri Tıp Bülteni 1993; 1:34-9.
12- Tecimer T, Tecimer C, Emre H, Temel İ, Üstün H, Karakaş S, Otlu A, Erpek S. Aflatoksin B1 (AFB1)’in tavşan karaciğeri üzerine etkileri: histopatolojik ve biyokimyasal değerlendirme. Ege Tıp Dergisi 1993; 32:45-8.
13- Tecimer C, Üstün M, Aladağ M, Ozdemir R, Yoloğlu S, Pehlivan E, Özdoğan M, Pınar T. Sigara ve yanmamış tütünün hematolojik parametreler üzerine etkileri. Türk Hematoloji-Onkoloji Dergisi 1993; 3:75-84.
14- Şahin G, Milcan A, Tecimer C, Kılıç A, Şahin B, Adezif kapsülit, diabetes mellitus ve Hba1c. Karadeniz Tıp Dergisi 1993; 6:187-9.
15- Tecimer C, Aladağ M, Özdemir R, Üstün M, Yoloğlu S, Pehlivan E, Ardıç S. Sigaranın akciğer fonksiyonları üzerine etkileri. Solunum Hastalıkları 1993; 4:231-8.
16- Tecimer C, Kızılkaya N, Özdemir R, Akın O, Tayfun E, Üstün H, Hilmioğlu F, Yücesoy M. Özofagus Crohn hastalığı. Gastroenteroloji 1993; 4:534-5.
17- Durmaz B, Tecimer C, Durmaz R, Kızılkaya N, Bozdemir F. Sigaranın serum IgA, IgG, ve IgM düzeylerine etkisi. Solunum Hastalıkları 1993; 4:239-43.
18- Tecimer C, Oto A. Hasta sinüs sendromu ile ankilozan spondilitin birlikte görüldüğü bir olgu. Kardiyoloji Bülteni 1993; 2:14-6.
19- Tecimer C, Tecimer T, Üstün H, Erpek G, Güngör S, Koral H, Bozkürk S. İnce iğne aspirasyon biyopsisinin tiroid lezyonlarının değerlendirilmesindeki yeri. Selçuk Üniversitesi Tıp Fakültesi Dergisi 1993; 9:183-90.
20- Tecimer C, Durmaz R, Durmaz B, Temel İ, Günal S. Hepatit A: Klinik ve subklinik olgular. Atatürk Üniversitesi Tıp Bülteni 1993; 25:61-5.
21- Tecimer C, Ardıç S, Pehlivan E, Yoloğlu S, Özdemir R, Aladağ M, Üstün M. Malatya Tekel tütün fabrikası işçilerinde solunum fonksiyonlarının araştırılması. İnonü Üniversitesi Turgut Özal Tıp Merkezi Dergisi 1994; 1:141-8.
22- Tecimer C, Durmaz R, Durmaz B, Aladağ M, Özdemir R, Günal S. Malatya’da çeşitli gruplarda “human immunodeficiency virus” infeksiyonu. Osmangazi Üniversitesi Tıp Fakültesi Dergisi 1994; 16:53-7.
23- Tecimer C, Üstün M, Aladağ M, Özdemir R, Yoloğlu S, Pehlivan S, Ardıç S. Lökosit ve trombosit sayıları, sigara içme ve akciğer fonksiyonları arasındaki ilişki. Tüberküloz ve Toraks 1995; 43:203-8.
24- Tecimer C, Üstün H, Güngör S, Koral H, Gönen S. Plevral effüzyon vakalarında klinik ve sitopatolojik değerlendirme. Karadeniz Tıp Dergisi 1996; 7(Suppl):1-5.
25- Üskent N, Demirbaş S, Türken O, Yıldırım Ş, Tecimer C, Kandemir G, Yaylacı M. Survival from the precocious brain metastasis of the colon cancer. The Turkish Journal of the Cancer 2003; 33: 154-157.
26- Breast Cancer Practice Pattern Study Group. Treatment approaches for metastatic breast cancer in Turkey. Turkish Journal of Cancer 2005; 35: 61-69.
4. Ulusal bilimsel toplantılarda sunulan ve bildiri kitabında basılan bildiriler
1-Tecimer C. Sinyal ileti inhibitörleri. XIV. Ulusal Kanser Kongresi, İstanbul, 30 Nisan-4 Mayıs, 2001. Bildiri Özetleri Kitabı 2001; sayfa 33.
2- Tecimer C. Kanser Hastalarında Farmakolojik Destek Tedavileri. Onkoloji Hemşireliği Hizmet İçi Eğitim Kursu, Marmara Üniversitesi Tıp Fakültesi Tıbbi Onkoloji Bilim Dalı, 3-6 Ekim, 2001, İstanbul. 1. Cilt 2001; sayfa 87-92.
3- İğdem Ş, Ercan T, Alço G, Tecimer C, Köksal G, Altun M, Turkan S, Okkan S. Yoğunluk ayarlı radyoterapi uygulanan baş-boyun kanserli olgularda akut yan etkiler. 17. Ulusal Kanser Kongresi, 19-23 Nisan, 2007, Antalya. Program ve Bildiri Özet Kitabı 2007; sayfa 90.
4- İğdem Ş, Alço G, Ercan T, Tecimer C, Köksal G, Altun M, Turkan S, Okkan S. Nazofarenks kanserinde yoğunluk ayarlı radyoterapi: Metropolitan Hastanesi deneyimi. 8. Ulusal Radyasyon Onkolojisi Kongresi, 19-23 Nisan 2008, Antalya. Bildiri Kitabı; 2008; sayfa 78.
5- Okutur K, Aydın KA, Demir N, Turan C, Tecimer C, Erdem L, Demir G. Metastatik kolorektal kanserde bevasizumab’ın toksisite profili. Poster sunusu. 18. Ulusal Kanser Kongresi, 21-26 Nisan 2009, Antalya. Program ve Bildiri Özet Kitabı 2009; sayfa 85.
6- Okutur K, Aydın K, Bozkurt M, Namal E, Demir N, Tecimer C, Demir G. Paraneoplastik dermatomiyozitle başvuran iki küçük hücreli akciğer kanseri olgusu. 3. Tıbbi Onkoloji Kongresi, 24-28 Mart 2010, Antalya. Bildiri Kitabı 2010; sayfa 30-1.
7- Okutur K, Aydın K, Bozkurt M, Namal E, Halefoğlu AM, Tekelioğlu MH, Demir G, Tecimer C. Küçük hücreli dışı akciğer kanserli bir hastada bevacizumab’a bağlı intestinal perforasyon. 3. Tıbbi Onkoloji Kongresi, 24-28 Mart 2010, Antalya. Bildiri Kitabı 2010; sayfa 31-2.
8- Okutur K, Aydın K, Bozkurt M, Namal E, Kurt B, Demir G, Tecimer C. Metastazektomi ile uzun süreli sağkalım sağlanan akciğer ve meme kanserli iki olgu. 3. Tıbbi Onkoloji Kongresi, 24-28 Mart 2010, Antalya. Bildiri Kitabı 2010; sayfa 50-1.
9- Namal E, Hasbal B, Akman C, Okutur K, Aydın K, Bozkurt M, Tecimer C, Demir G. Siklofosfamit ile ilişkili akut solunum yetmezliği sendromu. 3. Tıbbi Onkoloji Kongresi, 24-28 Mart 2010, Antalya. Bildiri Kitabı 2010; sayfa 51-2.
10- Okutur K, Aydın K, Bozkurt M, Namal E, Halefoğlu AM, Tekelioğlu MH, Tecimer C, Demir G. Bevacizumaba bağlı intestinal perforasyon-vaka serisi. 3. Tıbbi Onkoloji Kongresi, 24-28 Mart 2010, Antalya. Bildiri Kitabı 2010; sayfa 56-7.
11- Namal E, Hasbal B, İşçi H, Okutur K, Aydın K, Bozkurt M, Tecimer C, Demir G. Atipik metastazlarla seyreden üç meme kanseri olgusu. 3. Tıbbi Onkoloji Kongresi, 24-28 Mart 2010, Antalya. Bildiri Kitabı 2010; sayfa 93.
12- Okutur K, Aydın K, Bozkurt M, Namal E, Akman C, Mandel NM, Tecimer C, Demir G. Akciğer metastazlarında spontan regresyon görülen osteosarkom olgusu. 3. Tıbbi Onkoloji Kongresi, 24-28 Mart 2010, Antalya. Bildiri Kitabı 2010; sayfa 100-1.
13- Okutur K, Aydın K, Bozkurt M, Namal E, Kapran Y, Barlan M, Hasbal B, Tecimer C, Demir G. Patolojik ve klinik bir dilemma: intestinal berrak hücreli sarkom. 3. Tıbbi Onkoloji Kongresi, 24-28 Mart 2010, Antalya. Bildiri Kitabı 2010; sayfa 103.
14- Okutur K, Dane F, İlhan M, Seber S, Korkmaz T, Aydın K, Bozkurt M, Namal E, Turhal S, Tecimer C, Demir G. Metastatik mide kanserinde haftalık dosetaksel, sisplatin, 5-florourasil rejiminin etkinliği ve güvenilirliği. 3. Tıbbi Onkoloji Kongresi, 24-28 Mart 2010, Antalya. Bildiri Kitabı 2010; sayfa 114.
15- Okutur K, Aydın K, Bozkurt M, Namal E, Turan C, Doğusoy GB, Tecimer C, Demir G. Kemoterapi uygulanırken yaygın cilt metastazları gelişen mide kanserli bir olgu. 3. Tıbbi Onkoloji Kongresi, 24-28 Mart 2010, Antalya. Bildiri Kitabı 2010; sayfa 115-6.
16- Aydın K, Okutur K, Bozkurt M, Namal E, Girişken G, Aydın Ö, Kuday C, Tecimer C, Demir G. Beyin tutulumuyla prezente olan bilateral primer adrenal non-Hodgkin lenfoma. 3. Tıbbi Onkoloji Kongresi, 24-28 Mart 2010, Antalya. Bildiri Kitabı 2010; sayfa 135.
17- Hatırnaz T, Koç E, Kılıç M, Okutur K, Tecimer C, Demir G. Adjuvan kemoterapi alan meme kanserli hastaların beslenme alışkanlıkları ve vücut ağırlığındaki değişimler. 3. Tıbbi Onkoloji Kongresi, 24-28 Mart 2010, Antalya. Bildiri Kitabı 2010; sayfa 140-1.
18- Hatırnaz T, Koç E, Kılıç M, Okutur K, Tecimer C, Demir G. Epidermal büyüme faktörü inhibitörü tedavisi alan kanser hastalarında cilt toksisitesi. 3. Tıbbi Onkoloji Kongresi, 24-28 Mart 2010, Antalya. Bildiri Kitabı 2010; sayfa 141.
19- Hatırnaz T, Atay M, Koç E, Kılıç M, Okutur K, Tecimer C, Demir G. Kanser hastalarında periferik santral venöz port komplikasyonları. 3. Tıbbi Onkoloji Kongresi, 24-28 Mart 2010, Antalya. Bildiri Kitabı 2010; sayfa 144-5.
20- Okutur K, Başsülü N, Aydın K, Bozkurt M, Namal E, Öztürk A, Tecimer C, Mandel NM, Calay Z, Akçalı Z, Doğusoy GB, Demir G. Her 2 pozitif metastatik meme kanserinde Pten, P 27 ve PI3K ekspresyonunun prediktif ve prognostik önemi. 19. Ulusal Kanser Kongresi, 20-24 Nisan 2011, Antalya. Bildiri Kitabı 2011; sayfa 15.
21- Başaran G, Sağlam S, Tansan S, Demirel M, Gökmen E, Aktan S, Göker E, Kaban K, Saip P, Demir G, Bavbek S, Mandel N, Tecimer C, Turhal S, Garipoğlu M. Hormon reseptör pozitif tümörlü erken evre meme kanseri hastalarında 21-genlik rekürrens skorun tedavi kararı üzerinde etkisi: Çok merkezli retrospektif değerlendirme. 19. Ulusal Kanser Kongresi, 20-24 Nisan 2011, Antalya. Bildiri Kitabı 2011; sayfa 58.
22- Okutur K, Başsülü N, Aydın K, Bozkurt M, Namal E, Tecimer C, Mandel NM, Akçalı Z, Doğusoy GB, Demir G. Her2 pozitif metastatik meme kanserinde Pten, P 27 ve PI3K ekspresyonunun prediktif ve prognostik önemi. 21. Ulusal Patoloji Kongresi, 16-20 Kasım 2011, İzmir. Bildiri Kitabı 2011; sayfa 188.
23- Pilancı KN, Elbüken F, Göksel S, Okutur K, Ordu Ç, Tecimer C. İzole multipl pankreas metastazı saptanan renal hücreli karsinom olgusu. 20. Ulusal Kanser Kongresi, 19-23 Nisan, 2013, Antalya. Bildiri Özetleri Kitabı 2013; sayfa 183.
24- İğdem Ş, Alço G, Ercan T, Dinçer M, Sağlam S, Demir G, Tecimer C, Okkan S. Lokal ileri rektum kanserinde simultane integre boost tekniği ile neoadjuvan volümetrik modüle ark tedavisi: akut yan etkiler. 20. Ulusal Kanser Kongresi, 19-23 Nisan, 2013, Antalya. Bildiri Özetleri Kitabı 2013; sayfa 152.
25- Okutur K, Pilancı KN, Elbüken F, Ordu Ç, Balcı C, Atuğ F, Erdem L, Sağlam S, Tecimer C, Demir G. Atipik intraabdominal metastazla seyreden bir meme kanseri olgusu. 20. Ulusal Kanser Kongresi, 19-23 Nisan, 2013, Antalya. Bildiri Özetleri Kitabı 2013; sayfa 118-9.
26- Alço G, İğdem Ş, Dinçer M, Özmen V, Demir G, Köksal G, Tecimer C, Sağlam S, Pilancı KN, Yenice S, Tuzlalı S, Erdoğan Z, Uysal F, Selamoğlu D, Özaçmak İD, Bozdağan A, Okkan S. Meme kanseri tedavisi gören olgularımızda D vitamini eksikliği. 20. Ulusal Kanser Kongresi, 19-23 Nisan, 2013, Antalya. Bildiri Özetleri Kitabı 2013; sayfa 73-4.
27- Okutur K, Ordu Ç, Pilancı KN, Aydın K, Bozkurt M, Namal E, Öztürk A, Sağlam S, Tecimer C, Demir G. Parotis tümörlerinde hedefli tedavilerin etkinliğine dair iki olgu. 20. Ulusal Kanser Kongresi, 19-23 Nisan, 2013, Antalya. Bildiri Özetleri Kitabı 2013; sayfa 248-9.
28- Ordu Ç, Pilancı KN, Avcı N, Okutur K, Alço G, Demirhan Ö, Köksal Ü, Sağlam S, Tecimer C, Demir G. İki farklı sunitinib şeması tedavisi alan metastatik böbrek hücreli karsinomlu olguların retrospektif değerlendirmesi. İstanbul Bilim Üniversitesi 5. Onkoloji Günleri, 20-22 Aralık 2013, Sapanca. Bildiri Özetleri CD’si.
5. Kitap Bölümleri
1-Tecimer C. Anafilaksi. İliçin G, Ünal S, Biberoğlu K, Akalın S, Süleymanlar G. (Ed.) Temel İç Hastalıkları, Güneş Kitabevi, Ankara, 1996, 1859-62.
2- Tecimer C. Baş-Boyun Cildinin Melanom Dışı Kanserleri- Kemoterapi ve Biyolojik Tedavi. Engin K, Erişen L.(Ed.) Baş-Boyun Kanserleri, Nobel Tıp Kitabevleri, İstanbul, 2003, 599-602.
3- Tecimer C, Üskent N. AIDS ile İlişkili Tümörler. Aydıner A, Topuz E. (Ed.) Onkoloji El Kitabı, Astra Zeneca İlaç San. ve Tic. Ltd. Şti. Turgut Yayıncılık A.Ş., İstanbul, 2006, 520-30.
4-Üskent N, Tecimer C. Akut Lösemiler. Aydıner A, Topuz E. (Ed.) Onkoloji El Kitabı, Astra Zeneca İlaç San. ve Tic. Ltd. Şti. Turgut Yayıncılık A.Ş., İstanbul, 2006, 531-49.
5-Üskent N, Tecimer C. Kronik Miyelositer Lösemi. Aydıner A, Topuz E. (Ed.) Onkoloji El Kitabı, Astra Zeneca İlaç San. ve Tic. Ltd. Şti. Turgut Yayıncılık A.Ş., İstanbul, 2006, 550-7.
6-Üskent N, Tecimer C. Kronik Lenfositik Lösemi. Aydıner A, Topuz E. (Ed.) Onkoloji El Kitabı, Astra Zeneca İlaç San. ve Tic. Ltd. Şti. Turgut Yayıncılık A.Ş., İstanbul, 2006, 558-68.
7-Üskent N, Tecimer C. Hodgkin Lenfoma. Aydıner A, Topuz E. (Ed.) Onkoloji El Kitabı, Astra Zeneca İlaç San. ve Tic. Ltd. Şti. Turgut Yayıncılık A.Ş., İstanbul, 2006, 569-86.
8-Üskent N, Tecimer C, Kınay M. Hodgkin Dışı Lenfomalar. Aydıner A, Topuz E. (Ed.) Onkoloji El Kitabı, Astra Zeneca İlaç San. ve Tic. Ltd. Şti. Turgut Yayıncılık A.Ş. İstanbul, 2006, 587-614.
9-Üskent N, Tecimer C. Miyeloproliferatif Hastalıklar. Aydıner A, Topuz E. (Ed.) Onkoloji El Kitabı, Astra Zeneca İlaç San. ve Tic. Ltd. Şti. Turgut Yayıncılık A.Ş., İstanbul, 2006, 637-45.
10-Tecimer C. Kanser ve Anjiyogenez. Erol Ç. (Ed.) İç Hastalıkları, MN Medikal ve Nobel, Ankara, 2008, 271-5.
11-Tecimer C. Kanser Hastasında Hematolojik Sorunlar. Onat H, Mandel NM. (Ed.) Kanser Hastasına Yaklaşım, Tanı, Tedavi, Takipte Sorunlar, Yenilenmiş 2. Baskı, Nobel Tıp Kitabevleri, İstanbul, 2012, 137-45.
Başlıca İlgi Alanları
- Akciğer Kanseri
- Karsinom
- Karaciğer Tümörleri
- Ewing sarkomu
- Ağız Kanseri
- +56 a11y_sr_more_diseases
Görülen hasta/danışanlar
Hizmetler
Başlıca Hizmetler
Tıbbi Onkoloji Randevusu
Abide-İ Hürriyet Cad. No: 166, Şişli
İstanbul Florence Nightingale Hastanesi
Diğer Hizmetler
Abide-İ Hürriyet Cad. No: 166, Şişli
İstanbul Florence Nightingale Hastanesi
Abdominal Ultrasonografi
Abide-İ Hürriyet Cad. No: 166, Şişli
İstanbul Florence Nightingale Hastanesi
Afp Kan Testi(Alfa-Fetoprotein Kan Testi)
Abide-İ Hürriyet Cad. No: 166, Şişli
İstanbul Florence Nightingale Hastanesi
Ameliyatsız Kanser Tedavisi
Abide-İ Hürriyet Cad. No: 166, Şişli
İstanbul Florence Nightingale Hastanesi
Bilgisayarlı Tomografi Taraması(Bt)
Abide-İ Hürriyet Cad. No: 166, Şişli
İstanbul Florence Nightingale Hastanesi
Kanser Aşı Tedavisi
Abide-İ Hürriyet Cad. No: 166, Şişli
İstanbul Florence Nightingale Hastanesi
Kanser Görüntüleme Kanser Deteksiyonu
Abide-İ Hürriyet Cad. No: 166, Şişli
İstanbul Florence Nightingale Hastanesi
Kanser Tanı ve Tarama
Abide-İ Hürriyet Cad. No: 166, Şişli
İstanbul Florence Nightingale Hastanesi
Kanser Tedavisi
Abide-İ Hürriyet Cad. No: 166, Şişli
İstanbul Florence Nightingale Hastanesi
Kanser Tedavisi Sonrası Takip
Abide-İ Hürriyet Cad. No: 166, Şişli
İstanbul Florence Nightingale Hastanesi
Kanser Tedavisinde Akıllı İlaç Tedavisi
Abide-İ Hürriyet Cad. No: 166, Şişli
İstanbul Florence Nightingale Hastanesi
Kanser Tedavisinde Antikor Tedavisi
Abide-İ Hürriyet Cad. No: 166, Şişli
İstanbul Florence Nightingale Hastanesi
Kanser Tedavisinde Hormon İlaç Tedavisi
Abide-İ Hürriyet Cad. No: 166, Şişli
İstanbul Florence Nightingale Hastanesi
Kanserde Bağışıklık Sistemi Tedavisi
Abide-İ Hürriyet Cad. No: 166, Şişli
İstanbul Florence Nightingale Hastanesi
Kemoterapi
Abide-İ Hürriyet Cad. No: 166, Şişli
İstanbul Florence Nightingale Hastanesi
Kemoterapi Sırasında Beslenme
Abide-İ Hürriyet Cad. No: 166, Şişli
İstanbul Florence Nightingale Hastanesi
Kolon Kanseri Görüntüleme
Abide-İ Hürriyet Cad. No: 166, Şişli
İstanbul Florence Nightingale Hastanesi
Lökoferez
Abide-İ Hürriyet Cad. No: 166, Şişli
İstanbul Florence Nightingale Hastanesi
MRI
Abide-İ Hürriyet Cad. No: 166, Şişli
İstanbul Florence Nightingale Hastanesi
Normal Randevu
Abide-İ Hürriyet Cad. No: 166, Şişli
İstanbul Florence Nightingale Hastanesi
Perkütan Iğne Aspirasyonu
Abide-İ Hürriyet Cad. No: 166, Şişli
İstanbul Florence Nightingale Hastanesi
Perkütan Karaciğer Biyopsisi
Abide-İ Hürriyet Cad. No: 166, Şişli
İstanbul Florence Nightingale Hastanesi
Pet Tarama
Abide-İ Hürriyet Cad. No: 166, Şişli
İstanbul Florence Nightingale Hastanesi
Plazmaferez(Hemaferezis)
Abide-İ Hürriyet Cad. No: 166, Şişli
İstanbul Florence Nightingale Hastanesi
Tam Idrar Tahlili(Tit)
Abide-İ Hürriyet Cad. No: 166, Şişli
İstanbul Florence Nightingale Hastanesi
Tam Kan Sayımı-Hemogram
Abide-İ Hürriyet Cad. No: 166, Şişli
İstanbul Florence Nightingale Hastanesi
Diğer içerikler
Adres
Abide-İ Hürriyet Cad. No: 166, Şişli 34381
Uygunluk
Bu adres için online randevu takvimi mevcut değil
Görüşler yakında geliyor
İlk görüşü yazın
Prof. Dr. Coşkun Tecimer adlı sağlık profesyonelini ziyaret ettiniz mi? Ne düşündüğünüzü paylaşarak, diğer insanlara yardımcı olabilirsiniz.
Görüş ekleSıkça Sorulan Sorular
-
Coşkun Tecimer isimli uzmanın ana uzmanlık alanları nelerdir?Coşkun Tecimer, Tıbbi Onkoloji, Hematoloji. Size Coşkun Tecimer tarafından sunulan hizmetlerden bazılarını gösteriyoruz: Abdominal Ultrasonografi, Afp Kan Testi(Alfa-Fetoprotein Kan Testi), Bilgisayarlı Tomografi Taraması(Bt), Kanser Görüntüleme Kanser Deteksiyonu, Kemoterapi, Kolon Kanseri Görüntüleme, Lökoferez, MRI, Perkütan Iğne Aspirasyonu, Perkütan Karaciğer Biyopsisi.
-
Coşkun Tecimer adresi nerede?Coşkun Tecimer şuradaki hasta / danışanları görüyor: -
- Abide-İ Hürriyet Cad. No: 166 Şişli
-
Adresine gitmek zorunda kalmadan Coşkun Tecimer isimli uzmanla online görüşebilir miyim?Hayır, şu anda Coşkun Tecimer online danışmanlık hizmeti sunmuyor.
-
Randevunun sonunda Coşkun Tecimer isimli uzmana ödeme nasıl yapılır?Coşkun Tecimer, şu ödeme yöntemlerini kabul eder: Nakit, Kredi kartı.
-
Coşkun Tecimer hangi dilleri konuşuyor?Coşkun Tecimer ile İngilizce dilinde konuşabilirsiniz.
-
Coşkun Tecimer isimli uzmandan nasıl randevu alabilirim?Coşkun Tecimer bu adreste hangi saatlerin uygun olduğunu henüz belirtmedi. Takvimde hangi saatlerin müsait olduğunu öğrenmek için doğrudan Coşkun Tecimer ile iletişime geçmenizi öneririz.